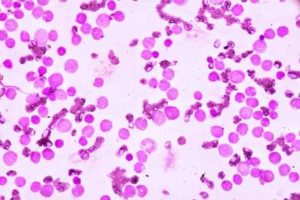

Tag: leucemia mieloide cronica

Leucemia mieloide cronica: rapida crescita causata da un singolo “HIT” genetico
Leucemia mieloide cronica-Immagine Credit Public Domain. Un nuovo studio ha svelato quando la leucemia mieloide cronica, un tipo di tumore…

Leucemia mieloide cronica: imparare a trattare il cancro alle radici
Perché alcuni tumori ritornano? A volte, un trattamento può eliminare efficacemente le cellule tumorali a livelli non rilevabili, ma, se…

La prostaglandina EI inibisce le cellule staminali della leucemia
Due farmaci, già approvati per l’uso nelle persone, potrebbero essere in grado di migliorare la terapia per la leucemia mieloide…
L’uso di antibiotici può aiutare a curare la leucemia mieloide cronica
La tigeciclina antibiotico, se utilizzata in combinazione con il trattamento attuale, può contenere la chiave per sradicare le cellule di…

Bosutinib è particolarmente adatto ai pazienti più anziani con leucemia mieloide cronica
Bosutinib, inibitore della tirosin- chinasi, sembra particolarmente adatto ai pazienti più anziani affetti da leucemia mieloide cronica, che hanno molteplici comorbidità,…
